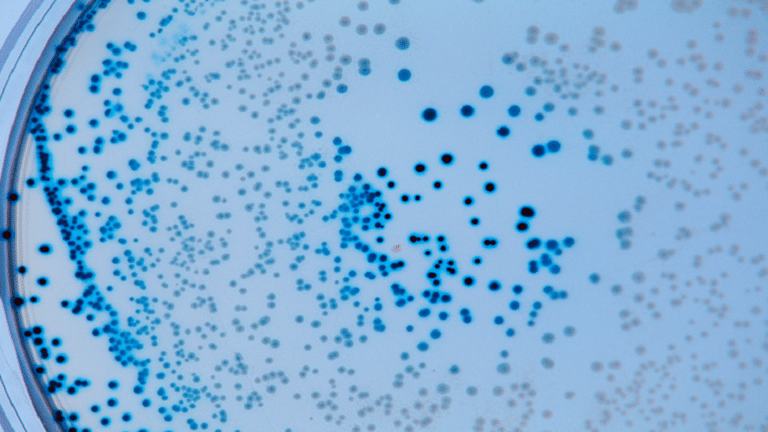

22 الاعلامي - تصطدم الفيروسات التي تسمى العاثيات بالبكتيريا منذ فترة طويلة قبل أن نوجد. لذا، ألقى باحثون من جامعة كاليفورنيا، سان دييغو، نظرة فاحصة على بعض "عاثيات جامبو" الأقل دراسة.
وتحديدا 201phi2-1 التي تصيب بكتيريا Pseudomonas chlororaphis.
وتم تسميتها لجينومها الكبير الذي يزيد عن 200000 زوج قاعدي (معظم العاثيات التي تصيب Pseudomonas لها جينومات أقل من 100000 زوج قاعدي)، وتمتلك "عاثيات جامبو" ترسانة من التقنيات لمواجهة آليات الدفاع البكتيري. ووجد البحث سابقا أن زراعة درع حول مادته الجينية كان أحد هذه الأساليب، ما يجعل دورة حياة هذه الفيروسات فريدة من نوعها.
وكتب عالم الأحياء الجزيئية توماس لافلين وزملاؤه في بحثهم الجديد، أن فصل المادة الجينومية عن باقي محتويات الخلية عن طريق تغليفها "كان يُعتقد سابقا أنها تطورت مرة واحدة فقط في تاريخ الحياة". لكن اتضح أن هؤلاء العمالقة الصغار هزمونا.
وتقول عالمة الفيزياء الحيوية إليزابيث فيلا: "إنها مقصورة من نوع مختلف - على عكس أي شيء رأيناه في الطبيعة على الإطلاق".
وعادة، تقوم العاثيات بحقن مادتها الجينية في البكتيريا حيث تطفو بحرية في المادة اللزجة الداخلية للخلية (السيتوبلازم) ويقوم الفيروس باختطاف معدات البكتيريا لتكرار نفسها. لكن "عاثيات جامبو" تقوم ببناء حجرة منفصلة حول حمضها النووي بعد وقت قصير من دخول مضيفها، يشبه إلى حد ما كيف تمتلك خلايانا نواة لحماية حمضنا النووي.
ويمنع هذا جسديا "نظام المناعة'' للبكتيريا CRISPR (نعم، إنه نفس الأنظمة التي اخترناها نحن البشر لأغراض التلاعب بالجينات الخاصة بنا) والإنزيمات الدفاعية الأخرى من العبث بالحمض النووي الفيروسي.
واستخدم لافلين وفريقهم الفحص المجهري الإلكتروني بالتبريد والتصوير المقطعي لفحص هذه الحجرة وصولا إلى المقياس الذري. وتم بناء الغلاف الواقي من نوع واحد فقط من البروتين.
وبمساعدة النمذجة الحاسوبية، وجد الباحثون أن نواة العاثية تسمح بشكل انتقائي للجزيئات بالمرور عبر مسام صغيرة - مرة أخرى على غرار الطريقة التي تتحكم بها الخلايا في البيئة المحيطة بموادنا الجينية، ما يجعل هذا مثالا رائعا للتطور المتقارب - عندما ينتهي الأمر بكائنات غير مرتبطة تماما مع حل مشابه لنفس المشكلة البيولوجية.
ويقول عالم الأحياء الخلوي جو بوجليانو: "الآن بعد أن علمنا أن بعض العاثيات لديها درع، يمكننا إعطاؤها لعاثيات أخرى ونصنع" عاثيات فائقة "أفضل في علاج العاثيات والتغلب على الدفاعات البكتيرية". والخطوة الأولى في هذه العملية هي فهم بنية بروتين الكيمالين الذي يتكون من الدرع، وهذا أحد أسباب أهمية هذا العمل".
ويتم بالفعل استخدام العلاج بالعاثيات لعلاج المرضى المصابين بعدوى بكتيرية خارقة بنجاح.
ونُشر هذا البحث في مجلة Nature.
المصدر: ساينس ألرت